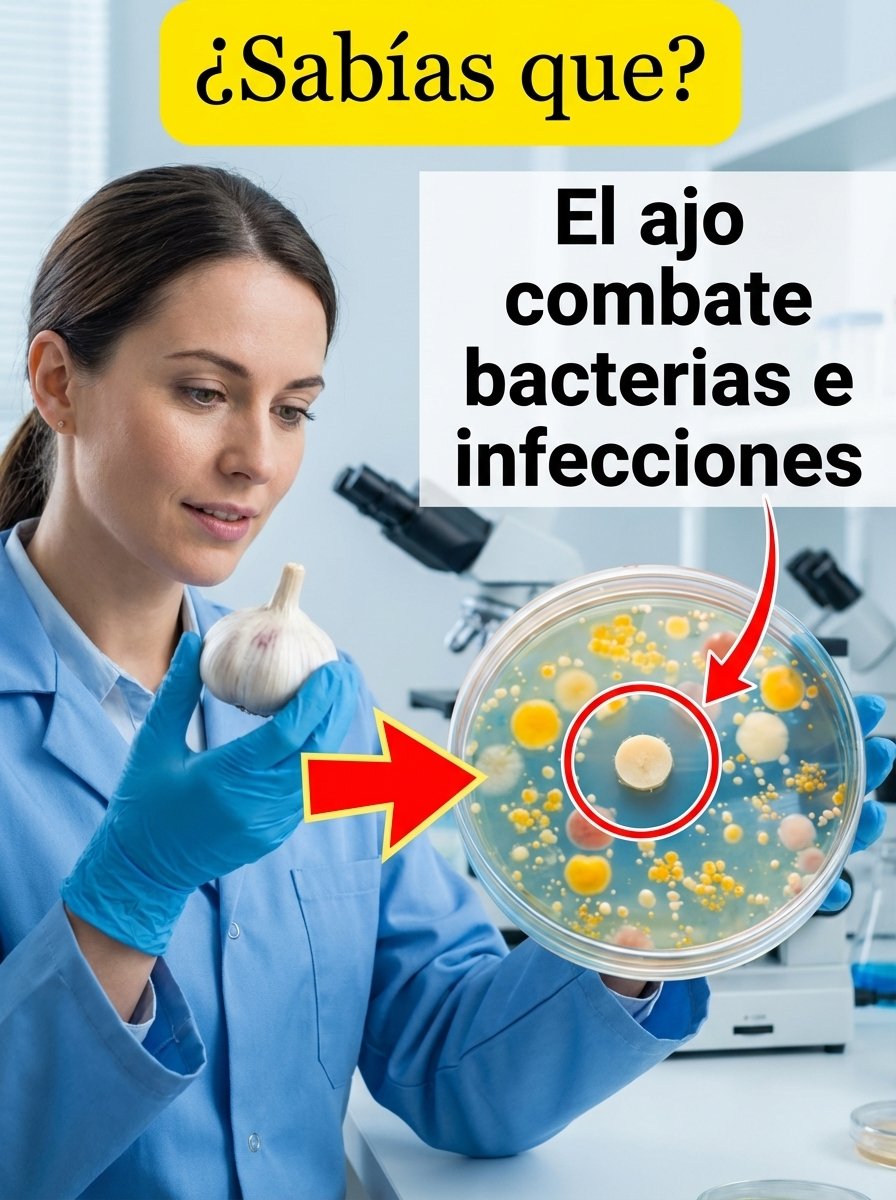
El Secreto del Ajo que NADIE te Cuenta: ¿Lo Estás Usando MAL contra las Bacterias?

¿Alguna vez te has preguntado si ese remedio casero con ajo que tu abuelita tanto alababa realmente funciona? Quizás te sientes incómodo con una molestia persistente o te preocupa una infección leve que no desaparece. La verdad es que, aunque el ajo es un superalimento, hay un secreto crucial sobre cómo usarlo para combatir bacterias que casi nadie conoce, y que podría cambiar por completo la forma en que cuidas tu salud. ¡No querrás perderte el detalle clave al final!
¿Qué es lo que hace al ajo tan fascinante para nuestra salud?
El ajo va mucho más allá de ser simplemente un pilar en la gastronomía mexicana y de otras culturas. En su interior, esconde una serie de compuestos naturales que han capturado la atención de la comunidad científica, siendo objeto de numerosos estudios por sus prometedores efectos en el bienestar.
Entre estos compuestos, destaca uno en particular: la alicina. Este potente elemento se libera de forma mágica cada vez que el ajo es cortado, machacado o triturado, desatando su potencial.
Pero aquí reside el verdadero giro…
Mientras el bulbo permanece intacto, la alicina no se encuentra en su estado más activo. Es precisamente al romper sus células cuando el ajo experimenta una “activación”, liberando sus propiedades. Esto explica por qué tantas recetas tradicionales insisten en la importancia de triturarlo o picarlo finamente antes de usarlo.
¿Qué nos revela la ciencia al respecto?
Diversas investigaciones y ensayos de laboratorio han arrojado luz sobre cómo ciertos componentes del ajo pueden ofrecer beneficios significativos:
• Ayudar a frenar el desarrollo de ciertas bacterias en entornos controlados.
• Contribuir al equilibrio y buen funcionamiento de nuestro sistema inmune.
• Actuar como un poderoso antioxidante, protegiendo nuestras células.
Sin embargo, es fundamental entender un punto crucial:
👉 Esto bajo ninguna circunstancia implica que el ajo deba reemplazar tratamientos médicos esenciales, ni que sus efectos sean idénticos en el complejo cuerpo humano que en las condiciones controladas de un laboratorio.
Y es precisamente aquí donde surge una confusión muy común entre las personas…
¿Por qué el ajo se ha convertido en el remedio casero favorito de todos?
En México, la tradición de utilizar el ajo con fines medicinales se ha transmitido de generación en generación. No es raro que tu mamá, tu abuela o alguna tía lo hayan recomendado fervientemente para múltiples dolencias.
Y esta popularidad no es una simple coincidencia.
El ajo reúne varias características que lo hacen ideal para el uso casero:
• Es extremadamente económico y accesible para todos los bolsillos.
• Se encuentra con facilidad en cualquier mercado o supermercado.
• Forma parte intrínseca de nuestra cultura culinaria y medicinal.
• Se asocia culturalmente con todo lo que es “natural” y benéfico.
Pero aquí viene una verdad que a veces resulta incómoda de aceptar…
👉 Que algo sea “natural” no siempre significa que sea suficiente o el tratamiento adecuado para todas las condiciones de salud.
Una comparación sencilla para que lo entiendas mejor
| Situación | El ajo podría ser un aliado | Se requiere atención médica profesional |
|---|---|---|
| Malestar leve o como medida preventiva | ✔️ Puede complementar hábitos saludables | ❌ |
| Infección que no cede o es persistente | ⚠️ Su apoyo es limitado y complementario | ✔️ |
| Síntomas intensos, agudos o que duran mucho | ❌ Definitivamente no es suficiente por sí solo | ✔️ |
La clave fundamental es discernir cuándo su uso es apropiado y cuándo es indispensable buscar la opinión de un profesional de la salud.
Beneficios reales del ajo que SÍ merecen tu atención
Llegamos a la sección que muchos estaban esperando, pero es crucial abordarla con una perspectiva realista y bien fundamentada.
El ajo puede ser un componente valioso y beneficioso dentro de un estilo de vida que prioriza la salud y el bienestar general.
Sus posibles aportaciones a tu salud
• Podría favorecer la salud de tu sistema cardiovascular.
• Es un aliado que puede contribuir a fortalecer tu respuesta inmune.
• Posee propiedades antioxidantes que combaten el daño celular.
• Puede ayudar a mantener un equilibrio microbiano saludable en tu organismo.
Pero la historia no termina aquí…
👉 Su mayor valor yace en su integración constante y regular dentro de una dieta balanceada y nutritiva, más que en considerarlo un “remedio milagroso” para problemas específicos.
¿Cómo sacar el máximo provecho al ajo?
• Una vez machacado, déjalo reposar entre 5 y 10 minutos antes de consumirlo o cocinarlo.
• Procura no cocinarlo en exceso, ya que las altas temperaturas pueden disminuir sus compuestos activos.
• Incorpóralo de forma habitual en tus comidas diarias, en lugar de reservarlo solo para cuando te sientas mal.
Pequeños ajustes en tu rutina… pueden generar una gran diferencia en tu bienestar.
¡ATENCIÓN! Riesgos y errores comunes al usar ajo (esto casi nadie te lo dice)
En este punto, es crucial hablarte con la franqueza de un médico de familia, sin adornos ni rodeos.
El ajo, a pesar de sus virtudes, no es adecuado para todas las personas ni en todas las dosis.
Errores que se cometen con frecuencia
• Consumirlo en cantidades exageradas, bajo la falsa creencia de que “más es siempre mejor”.
• Utilizarlo como un sustituto directo y único de la atención médica profesional cuando esta es necesaria.
• Aplicarlo directamente sobre la piel sin precauciones, lo que puede causar irritación.
• Tomarlo en ayunas sin haber comprobado previamente la tolerancia de tu estómago.
Posibles efectos no deseados que debes conocer
• Puede provocar irritación en el revestimiento estomacal.
• Un aliento fuerte y persistente, sí, ese que a veces resulta incómodo.
• Diversas molestias digestivas, como gases o acidez.
• Potenciales interacciones con ciertos medicamentos, alterando su efecto.
Y esto es especialmente relevante si has superado los 50 años…
👉 Tu organismo ya no procesa ciertos compuestos de la misma manera. Lo que antes tolerabas sin problemas, hoy podría causarte considerables molestias.
Cómo incorporar el ajo de forma segura y efectiva en tu día a día
Aquí te presento la información más práctica, aquella que puedes aplicar desde hoy mismo para mejorar tu bienestar.
Un plan sencillo paso a paso
- Consume de 1 a 2 dientes de ajo cada día, es una cantidad moderada y efectiva.
- Siempre machácalo y déjalo reposar unos minutos antes de integrarlo a tus preparaciones.
- Añádelo a tus sopas, guisos, ensaladas o verduras para potenciar su sabor y beneficios.
- Si sientes irritación estomacal, evita consumirlo crudo y opta por cocinarlo ligeramente.
- Presta atención a cómo reacciona tu cuerpo, cada organismo es único.
Pero hay un detalle crucial que a menudo se pasa por alto…
👉 La constancia en su consumo es mucho más relevante que la cantidad excesiva.
No necesitas exagerar. Simplemente sé constante y verás los resultados.
El secreto que casi nadie te ha contado sobre el ajo
Este es el punto clave que te prometí al inicio de este artículo, el detalle que puede marcar una verdadera diferencia.
Cuando prepares ajo, es fundamental que, después de machacarlo o picarlo, lo dejes reposar durante unos minutos antes de someterlo a cualquier cocción.
¿Y la razón detrás de este consejo?
Ese breve periodo de espera permite que se active y se forme adecuadamente la alicina, el compuesto del ajo al que se le atribuyen la mayoría de sus propiedades beneficiosas y el más estudiado por la ciencia.
Si lo cocinas inmediatamente después de picarlo…
👉 Estarás perdiendo una gran parte de su valioso potencial y sus beneficios.
Un pequeño cambio en tu preparación, un impacto gigantesco en tu salud.
Conclusión final
El ajo, sin duda, contiene compuestos fascinantes que pueden ser un gran apoyo para tu salud. Sin embargo, es vital comprender que no es una solución mágica para todo, ni debe reemplazar nunca la atención médica profesional cuando esta es indispensable. Su verdadero valor reside en integrarlo de manera inteligente, constante y con moderación en tu dieta diaria. Escuchar atentamente a tu cuerpo es primordial, ya que no todos reaccionamos de la misma manera ante sus efectos.